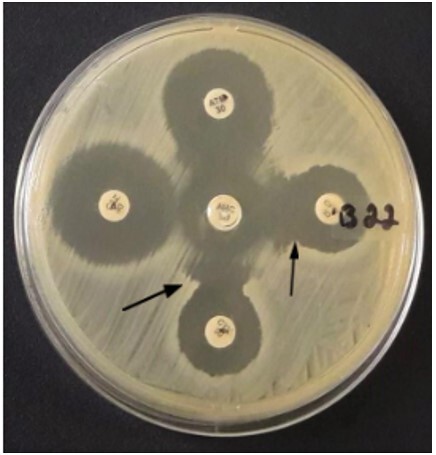

Abstract
The overuse of antimicrobials in poultry has led to the development and dissemination of multidrug-resistant bacteria in the poultry industry. One of the most effective mechanisms of resistance found in Escherichia coli is the production of extended-spectrum β-lactamases (ESBL); there are several ESBLs, including the TEM, SHV, and CTX-M families. This resistance mechanism and the risks associated with transmitting these resistant microorganisms between animals, the environment, and humans can occur through direct contact and consumption of infected animals. This study aimed to determine the prevalence of E. coli in samples isolated from three broiler farms in Rio de Janeiro, Brazil, and screen the isolates for ESBL genes. The findings of this study demonstrated the presence of ESBL-producing E. coli in all farms studied. The findings of this study highlight the urgency for a program to monitor the poultry industry value chains at the regional level to control the spread of antimicrobial resistance. Therefore, we recommend that the enzyme subtypes produced by bacterial isolates should be determined to effectively characterize the distribution of genes related to antimicrobial resistance.
Keywords: ESBL, Escherichia coli, poultry, antimicrobial resistance, one health
Resumo
O uso excessivo de antimicrobianos em frangos de corte tem contribuído para o desenvolvimento e disseminação de bactérias multirresistentes, e um dos mais relevantes mecanismos de resistência encontrados em Escherichia coli é a produção de enzimas denominadas β-lactamases de espectro estendido (ESBL). CTX-M, SHV e TEM são as β-lactamases mais comumente encontradas nesta espécie e as ESBL mais prevalentes globalmente. Esse mecanismo de resistência e o risco associado à transmissão desses microrganismos resistentes entre animais, meio ambiente e seres humanos se devem principalmente ao contato direto e ao consumo de origem animal. Este trabalho buscou elucidar a prevalência de E. coli em amostras de três granjas de frangos de corte localizadas no Rio de Janeiro, Brasil, e caracterizá-las de acordo com seu genótipo. O estudo demonstrou uma presença consistente de E. coli produtora de ESBL com presença abundante do gene bla SHV nos isolados de todas as fazendas estudadas. Deste modo, este estudo teve como objetivo contribuir com dados epidemiológicos relativos à distribuição de genes relacionados às β-lactamases na produção animal, conscientizando sobre a transmissão desses microrganismos resistentes entre animais, meio ambiente e seres humanos contribuindo com dados epidemiológicos e de sua importância em uma perspectiva de saúde única.
Palavras-chave: ESBL, Escherichia coli, frangos de corte, resistência antimicrobiana, saúde única
Introduction
Escherichia coli is a commensal bacterium and intestinal microbiota in several animals, such as birds, mammals, and humans. However, not all strains are harmless. E. coli can act as a pathogen in different host species at the intestinal or extra-intestinal level (Stromberg et al., 2017). The transmission of E. coli between humans and animals can occur through fecal-oral or by consuming contaminated food, mainly meat. Detecting bacteria in food is essential for public health due to the development of cases or outbreaks of food-borne diseases (Cormier et al., 2019; Melo et al., 2018). Brazilian poultry has been dramatically affected by infections, such as avian colibacillosis in broiler and laying birds caused by E. coli. These infections are the leading cause of complete condemnation of broiler carcasses in slaughterhouses under the Federal Inspection Service in the southern region of Brazil, resulting in substantial economic losses for producers and the entire production chain (Roth et al., 2019; Santiago et al., 2019). Brazil is one of the most important producers and exporters of chicken meat globally (United States Departament of Agriculture Foreign Agricultura, 2022), so these infectious diseases are of great economic and health concern. Antimicrobials are used as a growth promoter in farm environments, and biocides, sanitizers, and disinfectants are used in slaughterhouses. In some cases, these drugs are utilized as growth promoters, improving animals’ health, and productivity by controlling the broilers’ intestinal microbiota. However, the drug overuse might be deposited as antibiotic residues in foodstuffs and has contributed to the development of multidrug-resistant bacteria, which can spread through the production chain, reaching other animals and humans (Blaak et al., 2015; Brower et al., 2017; Marshall & Levy, 2011; Vounba et al., 2019).
To effectively address this concern, some actions taken by all sectors are essential to prevent the spread of these antimicrobial residues in food. For example, the drug withdrawal period is a priority to safeguard human health, and the need for poultry industries to establish antimicrobial control strategies in poultry products and related sources. In addition, they monitor the actions throughout the food chain sector (Saraiva et al., 2022).
Since 2016, the Ministry of Health in Brazil has implemented its National Action Plan (PAN-BR), accordant with the Global Action Plan, defined by the tripartite alliance on the “One Health” concept. This document involves several governmental spheres, including the Ministry of Health and Ministry of Agriculture, Livestock, and Supply (MAPA). The plan aimed at health education, epidemiological studies, surveillance, and monitoring of the use of antimicrobials, strengthening the prevention of infections, and implementing measures to control and promote the rational use of antimicrobials in animals. The MAPA with the regulations IN45/2016 and IN1/2020 prohibited using Colistin, Tylosin, Lincomycin, and Tiamulin as performance enhancers. The overuse of antimicrobials is expected to be reduced through the integrated activities proposed in the plan (Saraiva et al., 2022).
One of the most effective resistance mechanisms of antimicrobials identified in E. coli is the production of extended-spectrum β-lactamases (ESBL). The production of ESBL leads to resistance to third-generation cephalosporins and monobactam and is also frequently related to genes of plasmid origin that are transferable between different bacterial species (Skočková et al., 2015). Escherichia coli strains that produce ESBL have emerged as pathogens in birds and humans, and their transmission through the poultry food chain has been extensively studied (Nguyen et al., 2016).
ESBL are enzymes classified into several types, with CTX-M, SHV, and TEM being the most common in E. coli (Palmeira & Ferreira, 2020). These β-lactamases are encoded by the genes called bla, followed by the enzyme's phenotypic name. SHV-1, TEM-1, and TEM-2 are narrow-spectrum β-lactamases derived from changes in the TEM and SHV variants (Khosravi et al., 2013; Rahman et al., 2018). These genes have been detected in humans, animals, and the environment highlighting the need for a holistic approach to control the problem (Dorado-García et al., 2018; Rabello et al., 2020).
Several articles report the high rate of E. coli producing ESBL in poultry isolates worldwide (Botelho et al., 2015; Kar et al., 2015; Osman et al., 2018; Projahn et al., 2018). In Brazil, strains that produce the bla CTX-M and bla TEM-types genes stand out, mainly in the south and southeast regions. States such as São Paulo and Paraná have already reported resistant E. coli strains circulating at the human-animal-food-environment interface (Fuga et al., 2022). This study aimed to determine the prevalence of ESBL-producing E. coli strains in the samples from broilers and layers in three farms located in the Rio de Janeiro State, Brazil, owing to the effectiveness of their resistance mechanism and the risk associated with their transmission between livestock, the environment, and human beings.
Materials and methods
The samples were collected between April 2015 and March 2016 from three poultry farms in the State of Rio de Janeiro, Brazil, which comprise two intensive farms (poultry farm 01 and poultry farm 02) with a capacity of 30,000 and 40,000 chickens, respectively, and one free-range farm (poultry farm 03) which has a capacity of 17.000 chickens. The broiler farms were visited twice for sampling, and the egg-laying farm was visited once. At each sampling visit, fifteen tracheal and fifteen cloaca swabs were collected, collecting one hundred fifty swab samples from seventy-five animals. The mean age of the animals from which swabs were collected was 33 days in the intensive farms and 62 weeks in the free-range farm. Chickens that were not feeding at the time of sample collection were selected to avoid contamination of the sample with feed. The criteria and methodology used in the collection of material were approved by the Ethics Committee on the Use of Animals do Instituto de Veterinária da Universidade Federal Rural do Rio de Janeiro (CEUA IV - UFRRJ - nº 36664040915). The swabs were inoculated directly in selective media for Gram-negative bacteria (MacConkey agar - HiMedia® and Eosin Methylene Blue agar - HiMedia®). The plates were incubated at 37°C for 24 h. The colonies of lactose-fermenting bacteria in both media, also colonies with characteristic metallic green aspects in EMB (Koneman et al., 2012), were considered. After Gram stain, morphologicall characteristics confirmation as Gram negatives rods, and the colonies were submitted to Mass Spectrometry by Ionization and Matrix-Assisted Laser Desorption (MALDI-TOF LT MicroflexBruker, MALDI Biotyper 2.0, Bruker®) for identification as E. coli.
The antimicrobial susceptibility test was performed using the Kirby-Bauer diffusion disk technique on Muller-Hinton agar (HiMedia®) following the methodology suggested by the Clinical and Laboratory Standards Institute (2022). The strains were isolated from the cultures incubated for 24 h on Brain Heart Infusion agar (BHI-Merck®) at 35 °C and adjusted to the McFarland 0.5 scale. The following standard strains were used as controls for each test: Escherichia coli ATCC 25922 and Klebsiella pneumoniae ATCC 700603 (Clinical and Laboratory Standards Institute, 2022). We used specific penicillin and cephalosporin disks to evaluate the possible production of β-lactamases (penicillinases and cephalosporinases): amoxicillin (10 μg; Sensifar™), ceftazidime (30 μg; Sensifar™), cefoxitin (30 μg; Sensifar™), cefotaxime (30 μg; Sensifar™), aztreonam (30 μg; Sensifar ™), imipenem (10 μg; Sensifar™), cefepime (30 μg; Sensidisk™), and amoxicillin + clavulanic acid (30 μg; Sensifar™).
The strains that were resistant to third-generation cephalosporins (cefotaxime and/ or ceftazidime) but were susceptible to clavulanate associated with β-lactam (amoxicillin + clavulanic acid) and were suspected of producing extended-spectrum β-lactamases (ESBL). These strains were subjected to confirmatory double disk synergism tests (Brazilian Committee for Antimicrobial Sensitivity Tests, 2018). This methodology was used for phenotypic confirmation of ESBL production, and the positive strains in this test should be reported as confirmed producers of ESBL. This test was also performed for cefoxitin and clavulanate-resistant strains associated with β-lactam due to suspected co-production of the AmpC-like β-lactamase enzyme (Dandachi et al., 2018; Santiago et al., 2016).
The double disk synergism test (DDST) was performed following the CLSI (Clinical and Laboratory Standards Institute, 2022) and BrCast (Brazilian Committee for Antimicrobial Sensitivity Tests, 2018) current guidelines. The test involved placing an antibiotic-coated disk in the center of the Muller-Hinton agar plate containing the inoculum and amoxicillin + clavulanic acid. The disks containing cephalosporins (cefotaxime, ceftazidime, cefepime, monobactam, and aztreonam) were placed at a distance of 20 mm, from center to center of the disks. After incubation for 18 h at 35 ºC, observations were made. A positive result was indicated by the increase in the zone of inhibition of any cephalosporin disk toward the amoxicillin + clavulanic acid disk (Brazilian Committee for Antimicrobial Sensitivity Tests, 2022).
The thermal lysis methodology extracted the total bacterial DNA from all isolates. Briefly, each isolate was grown in 1.5 mL of BHI broth at 35 °C for 24 h, centrifuged for 2 min at 13500 × g, and the supernatant was discarded. The precipitate was resuspended in 200 µL of ultrapure water, vortexed, and incubated at 100 °C for 10 min. The microtubes were cooled to room temperature and centrifuged for 2 min at 13500 × g. About 180 µL of the supernatant was transferred to a new 600 µL microtube stored at -20 °C (Féria et al., 2002).
To verify the presence of the bla CTX-M, bla SHV, and bla TEM resistance genes, polymerase chain reaction (PCR) was performed in a 25 µL reaction volume containing 1 × reaction buffer, 2.5 mM MgCl2, 0.2 mM of each dNTP, 0.4 µM of each primer, 1 U of Taq DNA polymerase, and 2µL of DNA.
For the amplification of the bla CTX-M, bla SHV, and bla TEM genes, the primers described by Geser et al. (2012), Shahid (2010), and Spanu et al. (2002), respectively, were used (Table 1). The amplification conditions of the blaCTX-M, blaSHV, and bla TEM genes were optimized as follows: bla CTX-M (94 °C for 5 min, 30 cycles of 94 °C for 1 min, 58 °C for 1 min, 72 °C for 1 min, followed by a final elongation at 72 °C for 10 min); bla SHV and bla TEM (94 °C for 5 min, 40 cycles of 94 °C for 1 min, 55 °C for 1 min, and 72 °C for 1 min, followed by a final elongation at 72 °C for 5 min).
Table 1. Sequence of the used primers.
| Genes | Primers | Sequence |
|---|---|---|
| bla CTX-M | bla CTX-M F | AAAAATCACTGCGCCAGTTC |
| bla CTX-M R | CCGTCGGTGACGATTTTAGCC | |
| bla SHV | bla SHV F | TTTATCGGCCCTCACTCAAGG |
| bla SHV R | GCTGCGGGCCGGATAACG | |
| bla TEM | bla TEM F | ATGAGTATTCAACATTTCCGTG |
| bla TEM R | TTACCAATGCTTAATCAGTGAG |
The PCR products, including positive control of the internal laboratory stock and a negative control without DNA, were visualized under UV trans-illumination L-PIX EX (Loccus Biotecnologia).
Results
A total of 103 E. coli isolates were identified; 63% (65/103) were isolated from cloaca samples, and 37% (38/103) from trachea samples, which comprise 43.7% (45/103) isolates from poultry farm 01, 46.6% (48/103) from poultry farm 02 and 9.7% (10/103) from poultry farm 03.
Among the E. coli isolates, 51.4% (53/103) expressed resistance to at least one of the β-lactams antibiotics tested in the disk diffusion test. A total of 18.4% (19/103) isolates were identified as ESBL producers due to the resistance phenotype based on their resistance to amoxicillin/clavulanate and third-generation cephalosporins. The DDST tested the ESBL producers (19) for phenotypic confirmation of enzyme production. Of the nineteen isolates, 36.8% (07/19) were positive for DDST, confirming that they were ESBL producers (Figure 1).
Figure 1. Double Disk Synergism Testdisk synergism test (DDST) with positive results indicated by the increase in the zone of inhibition of cephalosporin disks toward the disc containing clavulanic acid (indicated by arrows).
The bla TEM, bla CTX-M, and bla SHV genes were screened in all 103 E. coli isolates. The bla SHV, bla TEM, and bla CTX-M genes were detected in 44.7% (46/103), 17.5% (18/103), and 10.7% (11/103) of the isolates, respectively.
The phenotypic test detected forty-four resistance patterns, the presence or absence of the beta-lactamases genes, and the prevalent phenogenotypic profile. A total of 30 isolates showed no resistance to the tested antimicrobials but had the bla SHV gene (Table 2).
Table 2. Characteristics of the differents phenogenotypic resistance pattern of ESBL-producing isolates found in this study.
| Resistance Profile | Origin | Genes | Resistance Phenotype | DDST | Samples |
|---|---|---|---|---|---|
| 1 | Trachea | blaTEM, blaSHV, blaCTX-M | AMO - CAZ * - CTX - ATM - C PM* | + | B178 |
| 2 | Trachea | blaSHV, blaCTX-M | AMO - CTX - ATM* - C PM | + | B23 |
| 3 | Trachea | blaTEM, blaCTX-M | AMO - CTX - C PM | + | B22 |
| 4 | Trachea | blaSHV, blaCTX-M | AMO - CTX- C PM* | B89 | |
| 5 | Trachea | blaTEM, blaSHV | CAZ - ATM - C PM* | B83 | |
| 6 | Trachea | blaTEM, blaSHV | AMO - CTX - IMP* | B180 | |
| 7 | Cloaca, Trachea | blaTEM, blaSHV | AMO | B14, B167 | |
| 8 | Cloaca | blaCTX-M | AMO - CAZ - CFO - CTX - C PM - ATM | + | B155 |
| 9 | Cloaca | blaCTX-M | AMO - CAZ* - CTX - C PM* - ATM* | B148 | |
| 10 | Trachea | blaCTX-M | AMO - CTX - ATM* - C PM | + | B29 |
| 11 | Trachea | blaSHV | CAZ - CFO -CTX - ATM - C PM | B25 | |
| 12 | Cloaca | blaSHV | AMO - CTX - ATM - C PM | + | B67B |
| 13 | Cloaca | blaCTX-M | AMO - CTX - C PM | B68B | |
| 14 | Cloaca | blaTEM | AMC- AMO - CAZ* - CFO* - CTX | B18 | |
| 15 | Cloaca | blaTEM | AMC - AMO - CFO - CTX* | B1 | |
| 16 | Trachea | blaSHV | AMO - CTX - ATM* - C PM | + | B177 |
| 17 | Cloaca | blaTEM | AMO - ATM* | B114 | |
| 18 | Cloaca | blaSHV | AMO - CTX | B201 | |
| 19 | Cloaca | blaTEM | AMO - C PM* | B4 | |
| 20 | Cloaca | blaSHV | IMP* | B216 | |
| 21 | Cloaca | blaTEM | IMP* | B67A | |
| 22 | Cloaca | blaCTX-M | AMO | B5 | |
| 23 | Cloaca | blaSHV | AMO | B6, B10, B55 | |
| 24 | Cloaca | blaTEM | AMO | B13, B146 | |
| 25 | Trachea | blaTEM | CTX* | B74 | |
| 26 | Cloaca | blaSHV | CTX* | B64 | |
| 27 | Trachea | blaTEM | CAZ* - C PM* | B75 | |
| 28 | Trachea | blaSHV | AMO* - CTX | B173 | |
| 29 | Cloaca | blaTEM, blaSHV | Sensitive to all tested antimicrobials | B15 | |
| 30 | Cloaca and Trachea | blaSHV | Sensitive to all tested antimicrobials | B16, B17, B42, B45, B57, B60,B66, B67C, B68A, B133, B138, B139, B141, B, 153, B157, B172, B200, B203, B205, B206, B207, B212, B213, B214, B215 | |
| 31 | Cloaca and Trachea | blaTEM | Sensitive to all tested antimicrobials | B69A, B72,B80, B93 | |
| 32 | Cloaca | Negative for genes | AMO - CFO - CTX - ATM* - C PM* | B65 | |
| 33 | Cloaca | Negative for genes | AMC - AMO - CAZ* - CFO - CTX | B61 | |
| 34 | Trachea | Negative for genes | CAZ* - CFO -CTX - ATM - C PM* | B86 | |
| 35 | Cloaca | Negative for genes | AMC - AMO - CFO* - CTX | B12 | |
| 36 | Cloaca | Negative for genes | CAZ* - CTX* - C PM* | B71 | |
| 37 | Cloaca | Negative for genes | AMC* - AMO - CFO* | B63 | |
| 38 | Cloaca | Negative for genes | AMO - CAZ - IMP | B8 | |
| 39 | Cloaca | Negative for genes | CTX - C PM* | B7 | |
| 40 | Cloaca | Negative for genes | AMC* - AMO | B56 | |
| 41 | Cloaca and Trachea | Negative for genes | AMO | B47, B53, B, 145, B147, B164 | |
| 42 | Cloaca | Negative for genes | IMP* | B51 | |
| 43 | Trachea and Cloaca | Negative for genes | CTX* | B35, B70 | |
| 44 | Trachea | Negative for genes | ATM | B87, B91 |
They presented intermediate resistance to the antimicrobial. Legend: AMO - amoxicillin, AMC - amoxicillin with clavulanic acid, CAZ - ceftazidime, CFO - cefoxitin, CTX - cefotaxime, ATM - aztreonam, CFM - cefepime, IMI - imipenem, DDST - Double Disk Synergism Test.
In poultry farm 01, 89% (40/45) of isolates had at least one gene. A total of 46.7% isolates (21/45) had the bla SHV gene, 24.4% (11/45) were positive for the bla TEM gene, and 17.8% (08/45) had the bla CTX-M gene (Figure 2). In this farm, a single isolate had all three resistance genes and showed a phenotypic confirmation of the enzyme production.
Figure 2. Genes responsible for producing extended-spectrum β-lactamases (ESBL) in chicken farm isolates.

At poultry farm 02, about 52% (25/48) of isolates had one of the genes, with 33.3% (16/48) being positive for the bla SHV, 14.6% (07/48) for the bla TEM, and 4.2% (02/48) for the bla CTX-M gene (Figure 2). Only one isolate from this farm showed phenotypic confirmation for ESBL production, presenting two genes (bla SHV and bla CTX-M).
At poultry farm 03, 100% (10/10) of isolates had at least one of the genes, with 90% (9/10) being positive for the bla SHV gene and 10% (1/10) for bla CTX-M. The bla TEM gene was not detected in this farm (Figure 2).
Discussion
The high prevalence of the bla SHV gene reported in this study in all three poultry farms was contrary to the findings of previous studies that reported a higher prevalence of the bla CTX-M gene in South America (Dahms et al., 2015; Rumi et al., 2019; Silva & Lincopan 2012; Tong et al., 2015). However, Alonso et al. (2017) confirmed the presence of the bla SHV gene in isolates from different sources and geographical origins. Also, they emphasized that SHV-like enzymes have already been reported as most prevalent in ESBL-producing Enterobacteriaceae in retail poultry and poultry meat, both in Germany and Spain.
The variability of different phenogenotypic resistance patterns and the fact that some samples demonstrated the resistance gene but not the phenotypic trait support the conclusions of Stokes et al. (2015). The phenotypic tests indicated the production of ESBL; however, the multiplicity of existing β-lactamases compromised its efficiency. Therefore, it is interesting to identify and distinguish the enzymes produced by their subtypes at the molecular level. Thus, although phenotypic tests are essential for identifying the genes expressed by the resistant strains, the frequency of ESBL production can be easily underestimated if there is no sequential genotype study. The presence of other β-lactamase enzymes, such as AmpC-type enzymes, may interfere with the synergism of clavulanate that occurs in the DDST. In such cases, applying double disk synergy tests that combine amoxicillin-clavulanate with cefepime can increase the probability of ESBL detection (Kaur et al., 2013). The resistance to cefoxitin found in patterns 8, 11, 14, and 15 also reinforces the possibility of AmpC-type enzymes, which confirmatory phenotypic tests based on supplemental cloxacillin will be developed later, followed by molecular methods.
According to the literature, among the 38 resistance patterns, were commonly associated with Pseudomonas aeruginosa. However, there was a weak association in E. coli (Neves et al., 2011; Senchyna et al., 2019), suggesting further molecular-based research to investigate possible resistance mechanisms.
E. coli isolates from broilers containing all three genes have been reported in a previous study by Dandachi et al. (2018). The presence of multiple resistance genes in isolated strains from broilers is essential, given that poultry residues are the second-largest disseminators of resistance genes compared to other animal breeds and human waste (He et al., 2020).
Despite the presence of the bla SHV gene in the farm 03 isolates, none of the strains demonstrated an ESBL production phenotype. This indicates the possibility of the presence and dissemination of the resistance genes even when the isolate does not show such characteristics in vitro. These findings confirm that molecular genotypic tests are essential for confirming isolates that are possible producers of ESBL. Although not all diagnostic laboratories perform genotypic tests in their laboratory routines.
The results on the prevalence of ESBL-producing E. coli in broiler samples in this study are consistent with those of several previous studies (e.g., Blaak et al., 2015; Brower et al., 2017; Kar et al., 2015; Wu et al., 2018), including some performed in Brazil (e.g., Ferreira et al., 2016; Rabello et al., 2020). According to Plaza Rodríguez et al. (2018), the high prevalence of ESBL-producing E. coli at all levels of the broiler production chain indicates that this production chain is one of the significant contributors to the selection and dissemination of these resistant bacteria.
The finding of this study highlights the importance of molecular genotypic detection tests, which confirm resistance patterns since many of the strains tested false negatives in the phenotypic test. In addition, these findings corroborate with the previous studies reporting the spread of the bla TEM, bla CTX-M, and bla SHV genes through E. coli in broilers in Rio de Janeiro. These E. coli isolates have often been obtained from human and animal samples upon consuming contaminated meat as a possible source for transmission to humans (Wu et al., 2018).
Conclusion
This study demonstrated the presence of ESBL-producing E. coli isolates in the broiler samples collected from poultry farms, indicating that poultry production chains are responsible for spreading antimicrobial resistance in Rio de Janeiro, Brazil. The prevalence of the bla SHV gene in poultry farms inspires further studies involving genotypic resistance profiling of microbial isolates. These findings highlight the need for a program to monitor the poultry value chains at the regional level for the spread of antimicrobial resistance. Therefore, the enzyme subtypes produced by bacterial isolates should be determined to effectively characterize the distribution of genes related to antimicrobial resistance.
Footnotes
How to cite: Patricio, T. C. C., Farias, B. O., Santiago, G. S., Souza, V. R. S., Pimenta, R. L., Oliveira, C. C., Coelho, I. S., Souza, M. M. S., & Coelho, S. M. O. (2022). Production of extended-spectrum beta-lactamases in Escherichia coli isolated from poultry in Rio de Janeiro, Brazil. Brazilian Journal of Veterinary Medicine, 44, e001722. https://doi.org/10.29374/2527-2179.bjvm001722
Ethics statement: The criteria and methodology used in the collection of material were submitted to and approved by the Ethics Committee on the Use of Animals (protocol No. 36664040915, Federal Rural University of Rio de Janeiro).
Financial support: TCCP, BOF, GSS, RLP and CCO - Received scholarship from CAPES (Coordenação de Aperfeiçoamento de Nível Superior). VRSS - Received scholarship from CNPq (Conselho Nacional de Desenvolvimento Científico e Tecnológico). ISC, MMSS and SMOC - FAPERJ (Fundação Carlos Chagas Filho de Amparo à Pesquisa do Estado do Rio de Janeiro).
Availability of complementary results: Open Acess.
The study was carried out at Laboratório de Bacteriologia Veterinálria/Departamento de Microbiologia e Imunologia Veterinária do Instituto de Veterinária da Universidade Federal Rural do Rio de Janeiro, Seropédica, RJ, Brasil.
References
- Alonso C. A., Michael G. B., Li J., Somalo S., Simón C., Wang Y., Kaspar H., Kadlec K., Torres C., Schwarz S. Analysis of bla SHV-12-carrying Escherichia coli clones and plasmids from human, animal and food sources. The Journal of Antimicrobial Chemotherapy. 2017;72(6):1589–1596. doi: 10.1093/jac/dkx024. [DOI] [PubMed] [Google Scholar]
- Blaak H., van Hoek A. H. A. M., Hamidjaja R. A., van der Plaats R. Q. J., Kerkhof-De Heer L., Husman A. M. R., Schets F. M. Distribution, numbers, and diversity of ESBL-producing E. coli in the poultry farm environment. PLoS One. 2015;10(8):e0135402. doi: 10.1371/journal.pone.0135402. [DOI] [PMC free article] [PubMed] [Google Scholar]
- Botelho L. A. B., Kraychete G. B., Costa e Silva J. L., Regis D. V. V., Picão R. C., Moreira B. M., Bonelli R. R. Widespread distribution of CTX-M and plasmid-mediated AmpC β-lactamases in Escherichia coli from Brazilian chicken meat. Memorias do Instituto Oswaldo Cruz. 2015;110(2):249–254. doi: 10.1590/0074-02760140389. [DOI] [PMC free article] [PubMed] [Google Scholar]
- Brazilian Committee for Antimicrobial Sensitivity Tests . EUCAST Guidelines for the detection of specific resistance mechanisms and resistances of clinical and/or epidemiological importance. BrCAST; 2018. BrCAST. http://brcast.org.br/documentos/ [Google Scholar]
- Brazilian Committee for Antimicrobial Sensitivity Tests . Tables of cut-off points for interpretation of CIMs and diameters of halos. BrCAST; 2022. BrCAST. [Google Scholar]
- Brower C. H., Mandal S., Hayer S., Sran M., Zehra A., Patel S. J., Kaur R., Chatterjee L., Mishra S., Das B. R., Singh P., Singh R., Gill J. P. S., Laxminarayan R. The prevalence of extended-spectrum beta-lactamase-producing multidrug-resistant Escherichia coli in poultry chickens and variation according to farming practices in Punjab, India. Environmental Health Perspectives. 2017;125(7):077015. doi: 10.1289/EHP292. [DOI] [PMC free article] [PubMed] [Google Scholar]
- Clinical and Laboratory Standards Institute . Performance standards for antimicrobial susceptibility testing: Document M100. 32nd. CLSI; 2022. CLSI. [Google Scholar]
- Cormier A., Zhang P., Chalmers G., Weese J. S., Deckert A., Mulvey M., McAllister T., Boerlin P. Diversity of CTX-M-positive Escherichia coli recovered from animals in Canada. Veterinary Microbiology. 2019;231:71–75. doi: 10.1016/j.vetmic.2019.02.031. [DOI] [PubMed] [Google Scholar]
- Dahms C., Hubner N. O., Kossow A., Mellmann A. Occurrence of ESBL-producing Escherichia coli in livestock and farm workers in Mecklenburg-Western Pomerania, Germany. PLoS One. 2015;10(11):e0143326. doi: 10.1371/journal.pone.0143326. [DOI] [PMC free article] [PubMed] [Google Scholar]
- Dandachi I., Sokhn E. S., Dahdouh E. A., Azar E., El-Bazzal B., Rolain J., Daoud Z. Prevalence and characterization of multi-drug-resistant gram-negative bacilli isolated from lebanese poultry: A nationwide study. Frontiers in Microbiology. 2018;9:550. doi: 10.3389/fmicb.2018.00550. [DOI] [PMC free article] [PubMed] [Google Scholar]
- Dorado-García A., Smid J. H., van Pelt W., Bonten M. J. M., Fluit A. C., van Den Bunt G., Wagenaar J. A., Hordijk J., Dierikx C. M., Veldman K. T., de Koeijer A., Dohmen W., Schmitt H., Liakopoulos A., Pacholewicz E., Lam T. J. G. M., Velthuis A. G., Heuvelink A., Gonggrijp M. A., van Duijkeren E., van Hoek A. H. A. M., Husman A. M. R. Molecular relatedness of ESBL/AmpC-producing Escherichia coli from humans, animals, food and the environment: A pooled analysis. The Journal of Antimicrobial Chemotherapy. 2018;73(2):339–347. doi: 10.1093/jac/dkx397. [DOI] [PubMed] [Google Scholar]
- Féria C., Ferreira E., Correia J. D. Patterns and mechanisms of resistance to beta-lactams and beta-lactamase inhibitors in uropathogenic Escherichia coli isolated from dogs in Portugal. The Journal of Antimicrobial Chemotherapy. 2002;49(1):77–85. doi: 10.1093/jac/49.1.77. [DOI] [PubMed] [Google Scholar]
- Ferreira J. C., Penha R. A. C., Filho, Andrade L. C., Berchieri A., Junior, Darini A. L. C. Evaluation and characterization of plasmids carrying CTX-M genes in a non-clonal population of multidrug-resistant Enterobacteriaceae isolated from poultry in Brazil. Diagnostic Microbiology and Infectious Disease. 2016;85(4):444–448. doi: 10.1016/j.diagmicrobio.2016.05.011. [DOI] [PubMed] [Google Scholar]
- Fuga B., Sellera F. P., Cerdeira L., Esposito F., Cardoso B., Fontana H., Moura Q., Cardenas-Arias A., Sano E., Ribas R. M., Carvalho A. C., Tognim M. C. B., de Morais M. M. C., Quaresma A. J. P. G., Santana Â. P., Reis J. N., Pilonetto M., Vespero E. C., Bonelli R. R., Cerqueira A. M. F., Sincero T. C. M., Lincopan N. WHO critical priority Escherichia coli as one health challenge for a post-pandemic scenario: Genomic surveillance and analysis of current trends in Brazil. Microbiology Spectrum. 2022;10(2):e01256-21. doi: 10.1128/spectrum.01256-21. [DOI] [PMC free article] [PubMed] [Google Scholar]
- Geser N., Stephan R., Hachler H. Occurrence and characteristics of extended-spectrum β-lactamase (ESBL) producing Enterobacteriaceae in food producing animals, minced meat and raw milk. BMC Veterinary Research. 2012;8(1):21. doi: 10.1186/1746-6148-8-21. [DOI] [PMC free article] [PubMed] [Google Scholar]
- He Y., Yuan Q., Mathieu J., Stadler S., Senehi N., Sun R., Alvarez P. J. J. Antibiotic resistance genes from livestock waste: Occurrence, dissemination, and treatment. NPJ Clean Water. 2020;3(1):4–11. doi: 10.1038/s41545-020-0051-0. [DOI] [Google Scholar]
- Kar D., Bandyopadhyay S., Bhattacharyya D., Samanta I., Mahanti A., Nanda P. K., Mondal B., Dandapat P., Das A. K., Dutta T. K., Bandyopadhyay S., Singh R. K. Molecular and phylogenetic characterization of multidrug resistant extended spectrum beta-lactamase producing Escherichia coli isolated from poultry and cattle in Odisha, India. Infection, Genetics and Evolution. 2015;29:82–90. doi: 10.1016/j.meegid.2014.11.003. [DOI] [PubMed] [Google Scholar]
- Kaur J., Chopra S., Sheevani G. M., Mahajan G. Modified double disk synergy test to detect ESBL production in urinary isolates of Escherichia coli and Klebsiella pneumoniae. Journal of Clinical and Diagnostic Research: JCDR. 2013;7(2):229–233. doi: 10.7860/JCDR/2013/4619.2734. [DOI] [PMC free article] [PubMed] [Google Scholar]
- Khosravi A. D., Hoveizavi H., Mehdinejad M. Prevalence of Klebsiella pneumoniae encoding genes for CTX-M-1, TEM-1 and SHV-1 Extended-Spectrum Beta Lactamases (ESBL) enzymes in clinical specimens. Jundishapur Journal of Microbiology. 2013;6(10):8256. doi: 10.5812/jjm.8256. [DOI] [Google Scholar]
- Koneman E. W., Allen S. D., Janda W. M., Schreckenberger P. C., Winn W. C., Junior . Diagnóstico microbiológico: Texto e atlas colorido. 6. Editora Médica e Científica; 2012. [Google Scholar]
- Marshall B. M., Levy S. B. Food animals and antimicrobials: Impacts on human health. Clinical Microbiology Reviews. 2011;24(4):718–733. doi: 10.1128/CMR.00002-11. [DOI] [PMC free article] [PubMed] [Google Scholar]
- Melo E. S., Amorim W. R., Pinheiro R. E. E., Corrêa P. G. N., Carvalho S. M. R., Santos A. R. S. S., Barros D. S., Oliveira E. T. A. C., Mendes C. A., Sousa F. V. Doenças transmitidas por alimentos e principais agentes bacterianos envolvidos em surtos no Brasil: Revisão. Pubvet. 2018;12(10):131. doi: 10.31533/pubvet.v12n10a191.1-9. [DOI] [Google Scholar]
- Neves P. R., Mamizuka E. M., Levy C. E., Lincopan N. Pseudomonas aeruginosa multirresistente: Um problema endêmico no Brasil. Bras Patol Med Lab. 2011;47(4):409–420. doi: 10.1590/S1676-24442011000400004. [DOI] [Google Scholar]
- Nguyen P., Nguyen T. A. D., Le T. H., Tran N. M. D., Ngo T. P., Dang V. C., Kawai T., Kanki M., Kawahara R., Jinnai M., Yonogi S., Hirai Y., Yamamoto Y., Kumeda Y. Dissemination of Extended-Spectrum β-Lactamase- and AmpC β-Lactamase-Producing Escherichia coli within the food distribution system of Ho Chi Minh City, Vietnam. BioMed Research International. 2016;2016:8182096. doi: 10.1155/2016/8182096. [DOI] [PMC free article] [PubMed] [Google Scholar]
- Osman K. M., Kappell A. D., Elhadidy M., Elmougy F., El-Ghany W. A. A., Orabi A., Mubarak A. S., Dawoud T. M., Hemeg H. A., Moussa I. M. I., Hessain A. M., Yousef H. M. Y. Poultry hatcheries as potential reservoirs for antimicrobial-resistant Escherichia coli: A risk to public health and food safety. Scientific Reports. 2018;8(1):5859. doi: 10.1038/s41598-018-23962-7. [DOI] [PMC free article] [PubMed] [Google Scholar]
- Palmeira J. D., Ferreira H. M. N. Extended-spectrum beta-lactamase (ESBL)-producing Enterobacteriaceae in cattle production - a threat around the world. Heliyon. 2020;6:03206. doi: 10.1016/j.heliyon.2020.e03206. [DOI] [PMC free article] [PubMed] [Google Scholar]
- Plaza Rodríguez C., Correia Carreira G., Käsbohrer A. A probabilistic transmission model for the spread of Extended-Spectrum-β-Lactamase and AmpC-β-Lactamase-Producing Escherichia coli in the broiler production chain. Risk Analysis. 2018;38(12):2659–2682. doi: 10.1111/risa.13145. [DOI] [PubMed] [Google Scholar]
- Projahn M., Daehre K., Semmler T., Guenther S., Roesler U., Friese A. Environmental adaptation and vertical dissemination of ESBL-/pAmpC-producing Escherichia coli in an integrated broiler production chain in the absence of an antibiotic treatment. Microbial Biotechnology. 2018;11(6):1017–1026. doi: 10.1111/1751-7915.13040. [DOI] [PMC free article] [PubMed] [Google Scholar]
- Rabello R. F., Bonelli R. R., Penna B. A., Albuquerque J. P., Souza R. M., Cerqueira A. M. F. Antimicrobial resistance in farm animals in Brazil: An update overview. Animals (Basel) 2020;10(4):552. doi: 10.3390/ani10040552. [DOI] [PMC free article] [PubMed] [Google Scholar]
- Rahman S., Ali T., Ali I., Khan N. A., Han B., Gao J. The growing genetic and functional diversity of extended spectrum beta-lactamases. Biomedical Research International. 2018;2018:9519718. doi: 10.1155/2018/9519718. [DOI] [PMC free article] [PubMed] [Google Scholar]
- Roth N., Kasbohrer A., Mayrhofer S., Zitz U., Hofacre C., Domig K. J. The application of antibiotics in broiler production and the resulting antibiotic resistance in Escherichia coli: A global overview. Poultry Science. 2019;98(4):1791–1804. doi: 10.3382/ps/pey539. [DOI] [PMC free article] [PubMed] [Google Scholar]
- Rumi M. V., Mas J., Elena A., Cerdeira L., Muñoz M. E., Lincopan N., Gentilini É. R., Di Conza J., Gutkind G. Co-occurrence of clinically relevant β-lactamases and MCR-1 encoding genes in Escherichia coli from companion animals in Argentina. Veterinary Microbiology. 2019;230:228–234. doi: 10.1016/j.vetmic.2019.02.006. [DOI] [PubMed] [Google Scholar]
- Santiago G. S., Motta C. C., Bronzato G. F., Gonçalves D., Souza M. M. S., Coelho I. S., Ferreira H. N., Coelho S. M. O. Revisão: Produção de β-lactamases do tipo AmpC em Enterobacteriaceae. Revista Brasileira de Medicina Veterinária. 2016;38(3):17–30. https://rbmv.org/index.php/BJVM/article/view/876 . [Google Scholar]
- Santiago G. S., Passarini J. F., Cerqueira J. A., Cunha H. V. F. Avaliação da reutilização de cama de frango sobre a condenação de carcaças por colibacilose. Pubvet. 2019;13(8):153. doi: 10.31533/pubvet.v13n8a392.1-6. [DOI] [Google Scholar]
- Saraiva M. M. S., Lim K., Monte D. F. M., Givisiez P. E. N., Alves L. B. R., Freitas O. C., Neto, Kariuki S., Berchieri A., Júnior, Oliveira C. J. B., Gebreyes W. A. Antimicrobial resistance in the globalized food chain: A one health perspective applied to the poultry industry. Brazilian Journal of Microbiology. 2022;53(1):465–486. doi: 10.1007/s42770-021-00635-8. [DOI] [PMC free article] [PubMed] [Google Scholar]
- Senchyna F., Gaur R. L., Sandlund J., Truong C., Tremintin G., Kultz D., Gomez C. A., Tamburini F. B., Andermann T., Bhatt A., Tickler I., Watz N., Budvytiene I., Shi G., Tenover F. C., Banaei N. Diversity of resistance mechanisms in carbapenem-resistant Enterobacteriaceae at a health care system in Northern California, from 2013 to 2016. Diagnostic Microbiology and Infectious Disease. 2019;93(3):250–257. doi: 10.1016/j.diagmicrobio.2018.10.004. [DOI] [PMC free article] [PubMed] [Google Scholar]
- Shahid M. Citrobacter spp. simultaneously harboring bla CTX-M, bla TEM, bla SHV, bla AmpC, and insertion sequences IS26 and orf513: An evolutionary phenomenon of recent concern for antibiotic resistance. Journal of Clinical Microbiology. 2010;48(5):1833–1838. doi: 10.1128/JCM.01467-09. [DOI] [PMC free article] [PubMed] [Google Scholar]
- Silva K. C., Lincopan N. Epidemiologia das betalactamases de espectro estendido no Brasil: Impacto clínico e implicações para o agronegócio. Jornal Brasileiro de Patologia e Medicina Laboratorial. 2012;48(2):91–99. doi: 10.1590/S1676-24442012000200004. [DOI] [Google Scholar]
- Spanu T., Luzzaro F., Perilli M., Amicosante G., Toniolo A., Fadda G. Occurrence of extended-spectrum beta-lactamases in members of the family Enterobacteriaceae in Italy: Implications for resistance to beta-lactams and other antimicrobial drugs. Antimicrobial Agents and Chemotherapy. 2002;46(1):196–202. doi: 10.1128/AAC.46.1.196-202.2002. [DOI] [PMC free article] [PubMed] [Google Scholar]
- Stokes A., O’brien G., Beaman M. H. Extended spectrum beta-lactamase testing of community Enterobacteriaceae in the west of Australia: Poor performance of phenotypic methods. Pathology. 2015;47(2):161–164. doi: 10.1097/PAT.0000000000000226. [DOI] [PubMed] [Google Scholar]
- Stromberg Z. R., Johnson J. R., Fairbrother J. M., Kilbourne J., van Goor A., Curtiss 3rd R., Mellata M. Evaluation of Escherichia coli isolates from healthy chickens to determine their potential risk to poultry and human health. PLoS One. 2017;12(7):e0180599. doi: 10.1371/journal.pone.0180599. [DOI] [PMC free article] [PubMed] [Google Scholar]
- Tong P., Sun Y., Ji X., Du X., Guo X., Liu J., Zhu L., Zhou B., Zhou W., Liu G., Feng S. Characterization of antimicrobial resistance and extended-spectrum β-lactamase genes in Escherichia coli isolated from chickens. Foodborne Pathogens and Disease. 2015;12(4):345–352. doi: 10.1089/fpd.2014.1857. [DOI] [PubMed] [Google Scholar]
- United States Departament of Agriculture Foreign Agricultura . Livestock and poultry: World markets and trade. USDA; 2022. USDA. [Google Scholar]
- Vounba P., Arsenault J., Bada-alambédji R., Fairbrother J. M. Pathogenic potential and the role of clones and plasmids in beta-lactamase-producing E. coli from chicken faeces in Vietnam. BMC Veterinary Research. 2019;15(1):106. doi: 10.1186/s12917-019-1849-1. [DOI] [PMC free article] [PubMed] [Google Scholar]
- Wu C., Wang Y., Shi X., Wang S., Ren H., Shen Z., Wang Y., Lin J., Wang S. Rapid rise of the ESBL and mcr-1 genes in Escherichia coli of chicken origin in China, 2008-2014. Emerging Microbes & Infections. 2018;7(1):30. doi: 10.1038/s41426-018-0033-1. [DOI] [PMC free article] [PubMed] [Google Scholar]
